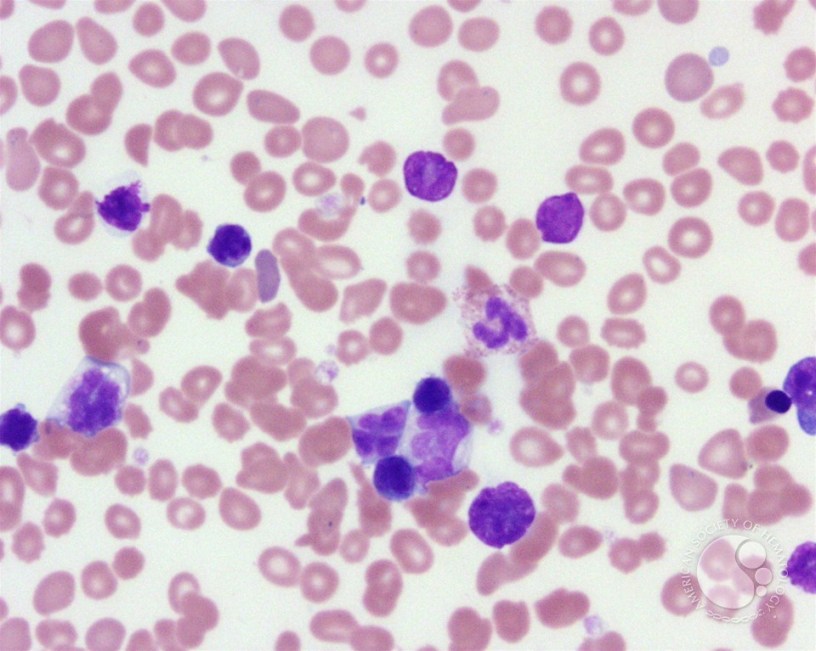

What up, nerds! Dr. Science here again, today to talk to you about Kymriah. Never heard of it? How about tisagenlecleucel? No? Well shut the fuck up and let me teach you something. Especially you, Randy. Thank you.
Kymriah is a novel therapy for ALL (Acute Lymphoblastic Leukemia) that the MFFDA (Mother Fucking Food and Drug Administration) just approved. ALL, like all leukemias, is an overproliferation of the precursors to certain white blood cells in the bone marrow. But, you say, white blood cells are the things that fight infection, right? So what’s the problem? Well, much like that fourth helping of marshmallow-topped sweet potatoes at Thanksgiving, you can have too much of a good thing. These excessive white blood cells spread to and interfere with other organ systems, including the liver, spleen, and even brain and spinal cord. It progresses rapidly, and can be fatal in just a few months if left untreated. In other words, it sucks. Hard.
Traditionally, this cancer has been treated with chemotherapy. There’s an old saying that the difference between medicine and poison often comes down to dosage; chemotherapy gets about as close to that line as possible. This class of drugs targets DNA (the annoying molecule from that totally unnecessary intro video at Jurassic Park) in rapidly dividing cells. While this targets little shits like cancer cells (fuck yeah!), it also affects hair cells and cells lining the digestive tract (fuck ye…oh, wait, no). This makes the patient feel, in technical terms, “like total shit.” It’s a balancing act of trying to poison the body just enough to kill the cancer cells without shutting down the whole system. The other standard treatment for leukemia is a bone marrow transplant, which involves purposefully killing all of your bone marrow with radiation, and really hoping the donor stem cells stick.
How do we end up with these craptastic diseases in the first place? In addition to their jobs that keep you alive and functioning, every cell is programmed to divide, and eventually die. When something screws up the DNA, it can turn off the “stop dividing” genes (these are called oncogenes), and instead of “divide,” the mission becomes “divide and conquer.” This can be from random, natural mistakes in the replication process, the effects of chemicals on the DNA, or radiation (you can’t get superpowers from radioactive animals biting you; related, I’m no longer welcome at the zoo). However, the body accounts for it. Frequently, these mutations happen in healthy people, but the immune system has evolved to detect these Genghis Khan cells and destroy them. Cancer arises when these cells mutate AND learn how to hide from the immune system.
Their days of hiding are, hopefully, limited. Thanks to Really Smart People, researchers at Novartis have developed a way to tell the immune system that those cells ain’t right. Kymriah involves taking a patient’s own T-cells (a type of white blood cell), and genetically modifying them to bind to a specific protein found on cancerous cells from ALL. The T-cells can then target these cells (and only these cells) and destroy them. What makes this treatment so impressive is that, instead of starting from scratch, they are recruiting the body’s own finely tuned system and giving it a nudge in the right direction.
I’d love to tell you this treatment is perfect. It’s perfect! Ahhh, that was nice.
Now for the truth: one treatment costs $475,000 (That’s more than the U.S. President makes in a year). Novartis has said they will not charge if the patient does not respond to treatment, and the price is comparable to bone marrow transplants. It does have potential side effects, including sudden drastic drops in blood pressure. Only certified physicians will be able to administer Kymriah.
Despite these obstacles, this is a huge fucking deal. For the first time, we are using precise genetic manipulations to specifically target cancer cells, instead of crudely destroying them with chemotherapy and radiation. But instead, you all are discussing the latest episode of Rick and Morty.
That was a damn good episode though, huh?
Sources:
https://www.fda.gov/NewsEvents/Newsroom/PressAnnouncements/ucm574058.htm
https://www.nytimes.com/2017/08/30/health/gene-therapy-cancer.html
https://www.cancer.org/cancer/acute-lymphocytic-leukemia/about/what-is-all.html